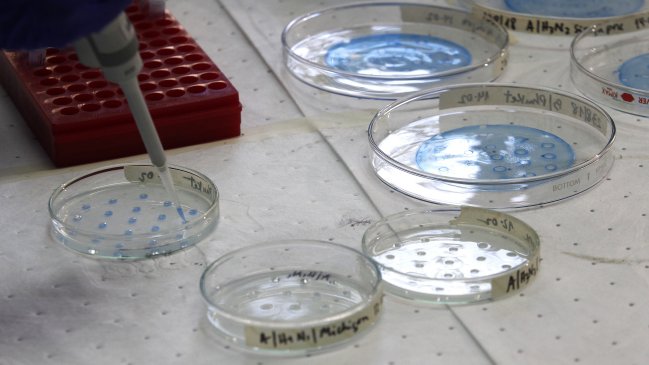
Fiebre amarilla: La próxima semana llegarán 15 mil dosis de vacuna a Chile

El Gobierno confirmó que la última semana de febrero llegarán 15 mil dosis de vacunas contra la fiebre amarilla, frente a la alta demanda debido al brote producido, principalmente, en Brasil, donde dos chilenos han muerto producto del contagio.
La ministra de Salud, Carmen Castillo, confirmó que "la próxima semana estarían llegando 15 mil dosis adicionales, sin embargo, hay muchas personas que se están vacunando no teniendo la necesidad, por el hecho de que hay lugares de Brasil en donde no se presenta la vacunación como requisito para ingresar".
Según detalló la autoridad, el próximo cargamento llegará en mayo y a fines del 2018 arribará un nuevo stock de vacunas para los viajeros.
En cuanto a la disponibilidad actual de vacunas, en la Clínica Santa María, el Hospital Clínico de la Universidad de Chile y el Hospital Clínico de la Universidad Católica no hay stock, mientras que en la Clínica Las Condes sólo lo hay para personas que ya pagaron la dosis y, por lo tanto, tienen hora asegurada.
La Organización Mundial de la Salud (OMS) asegura que una sola dosis de la vacuna da inmunidad a esta enfermedad de por vida, por lo que recomendación es adquirirla hasta 10 días antes de viajar a la zona.
Lee también: Qué es y cómo prevenir la fiebre amarilla
Las zonas de mayor riesgo en Brasil
Brasil registró 545 casos confirmados de fiebre amarilla desde julio de 2017, de los cuales 164 resultaron en muertes, según informó ayer el ministerio de Salud de ese país.
El estado de Minas Gerais fue la localidad brasileña con el mayor número de diagnósticos, contabilizando 264 casos y 77 óbitos, seguido de Sao Paulo, con 208 ocurrencias y 57 muertes, y Río de Janeiro (72 casos y 29 fallecimientos).
En todos los casos, la variedad de fiebre amarilla detectada es la del tipo silvestre, transmitida por mosquitos de las especies Haemagogus y Sabethes, presentes en zonas boscosas.
Desde 1942, Brasil no registra casos de la fiebre amarilla de tipo urbano, que es transmitida por el mosquito Aedes aegypti, el vector del dengue, el zika y el chikunguña.
Sin embargo, el Instituto Evandro Chagas, vinculado al Ministerio de Salud, ha conseguido en el último año detectar el virus de fiebre amarilla en mosquitos Aedes albopictus, popularmente conocido como "Tigre Asiático", y estudia actualmente si se ha convertido en un nuevo transmisor de la enfermedad.